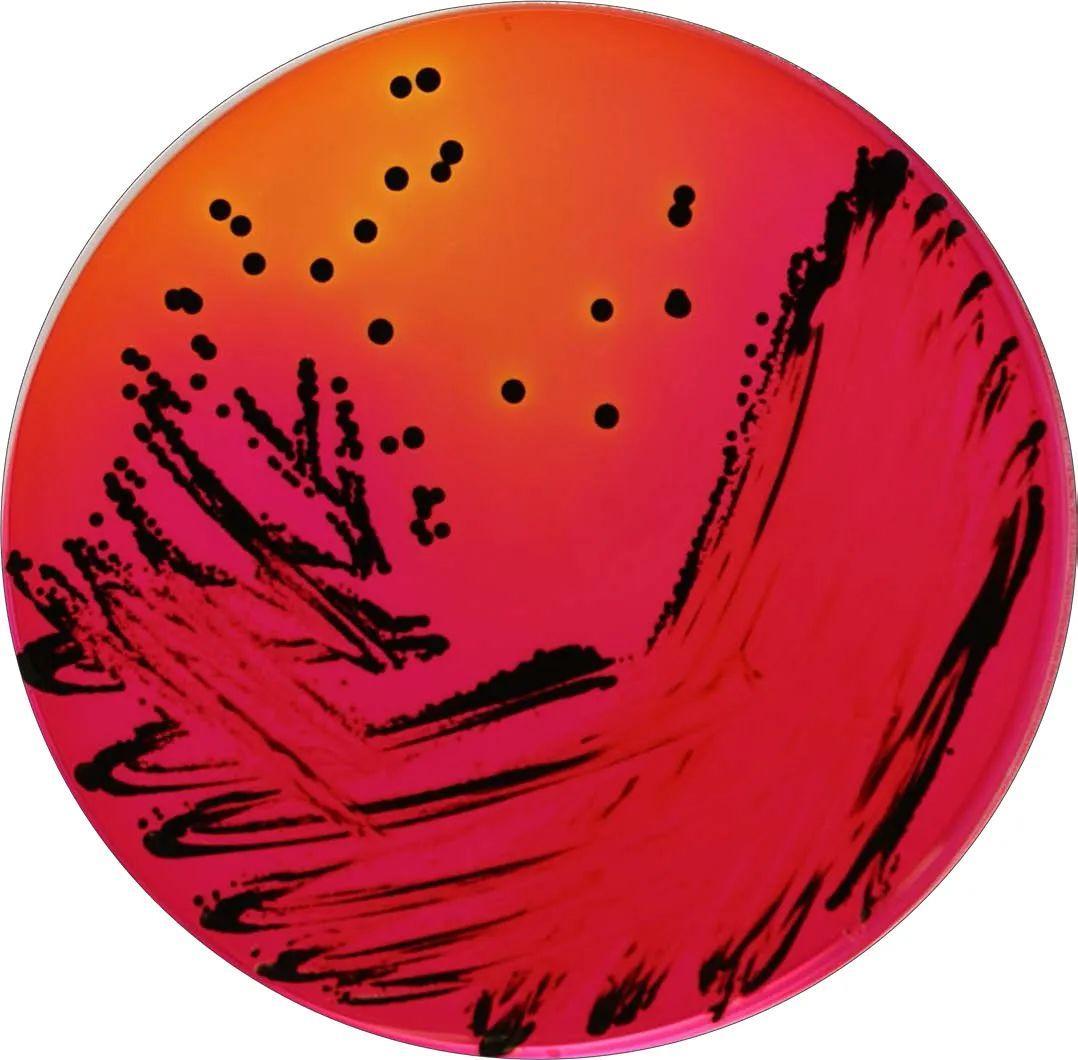

北大荒的宝地-宝清
2025-01-14 21:24:27
常用培养基的灭菌(除菌)方式及注意事项
01湿热灭菌
湿热灭菌系指将物品置于灭菌设备内利用饱和蒸汽、蒸汽-空气混合物、蒸汽-空气-水混合物、过热水等手段使微生物菌体中的蛋内质、核酸发生变性而杀灭微生物的方法。该法灭菌能力强,为热力灭菌中最有效、应用最广泛的灭菌方法。药品、容器、培养基、无菌衣、胶塞以及其他遇高温和潮湿性能稳定的物品,均可采用湿热灭菌方法灭菌。
湿热灭菌适用于大部分培养基的灭菌。用湿热灭菌方法对培养基灭菌时,加热的温度和时间对微生物死亡和营养成分的破坏均有影响。灭菌时间不宜过长,否则有机物质例如氨基酸、糖类、维生素等营养物质会在高温下分解,失去营养作用,导致培养基变质、变色,琼脂类培养基不凝固等。

湿热灭菌工艺的开发应考虑被灭菌物品的热稳定性、热穿透性、生物负载等因素。对于无菌要求很高的培养基,例如无菌检查用培养基、微生物计数等非选择性培养基的,湿热灭菌通常采用温度-时间参数或者结合F0值(F0值为标准灭菌时间,系灭菌过程赋予被灭菌物品121°C 下的等效灭菌时间)综合考虑,确保物品灭菌后达到符合要求的无菌保障水平。同时也要保证培养基的性能(PH、灵敏度、促生长能力)符合要求。例如FTM、TSB等。
对于比较特殊的培养基,例如:RV沙门增菌液体培养基(孔雀绿的主要用途是抑制大肠菌群等非沙门菌的生长;六水合氯化镁除了提供必需的离子之外,还可以抑制变形杆菌和大肠杆菌的生长),药典规定灭菌温度不能超过115℃,原因是该培养基含有氯化镁。氯化镁纯品为无色单斜结晶,溶于水,100℃时失去2分子结晶水。常温下其水溶液呈中性。在110℃开始失去部分氯化氢而分解,强热转为氧氯化物,当急速加热时约118℃分解。
市面上常见的RV的灭菌参数为115℃,15min或20min,这个程序并不是严格的过度灭杀法,在制定灭菌程序时,应重点考虑培养基的性能。
02加热煮沸
紫红胆盐葡萄糖琼脂培养基(VRBGA)和木糖赖氨酸脱氧胆酸盐琼脂培养基(XLD)是鉴定性培养基,具有较强的选择性,对微生物来说具有有特异性,能抑制大部分细菌的生长,所以无需高温高压灭菌,仅需加热使琼脂完全溶解。
注意事项:在制备VRBGA和XLD时,不建议一直处于煮沸状态,开始沸腾时,离开热源,待稍冷却后,继续加热至沸腾,重复3-4次,直至完全溶解,澄清透明无琼脂颗粒。即可以防止培养基暴沸溢出,也可以避免水分大量挥发

灰藻生物
专注于微生物、细胞和分子生物资源的开发和交流
兼有ATCC原装菌株
和ScienCell原代细胞代理等技术服务
致力于为任何有需要的客户
提供专业、稳定、优质的生物资源
争做“生命科学研究的好伙伴”
2025-01-14 21:24:27
2025-01-14 21:22:13
2025-01-14 21:19:59
2025-01-14 21:17:45
2025-01-14 21:15:30
2025-01-14 21:13:16
2025-01-14 21:11:02
2025-01-14 21:08:48
2025-01-14 21:06:33
2025-01-14 21:04:19
2025-01-14 21:02:05
2025-01-14 20:59:51
2025-01-14 14:50:11
2025-01-14 14:47:57
2025-01-14 14:45:42
2025-01-14 14:43:28
2025-01-14 14:41:14
2025-01-14 14:39:00
2025-01-14 14:36:45
2025-01-14 14:34:31